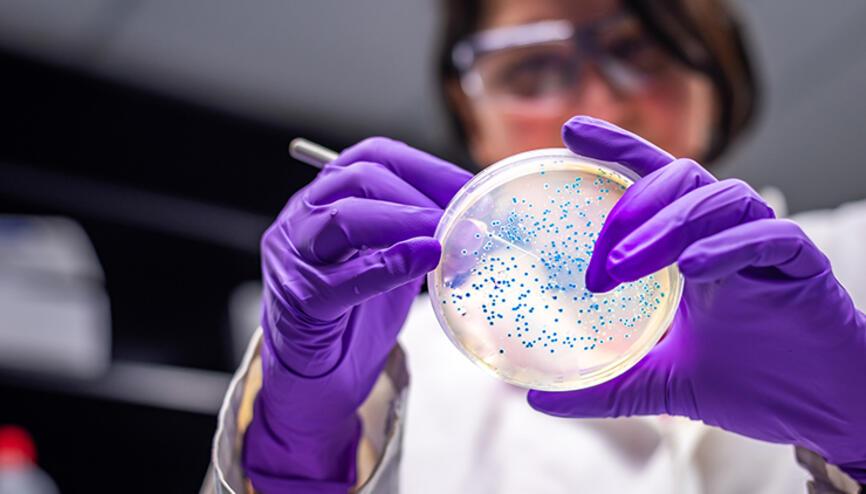
Bilim insanlari uyardi: Dünyadaki bir numarali ölüm nedeni haline geldi!

Kış geldi, hastalıklar arttı: Korunmak için bunu sakın yapmayın!

PeyamaKurd - Kış geldi, soğuklar bastırdı. Hâl böyle olunca üst solumun yolu vakalarında artış başladı. Vatandaşlar hastalıklardan korunmak için takviyelere başvururken, doktorlar uyarıyor: Bilinçsiz takviye kullanımı çok ciddi sonuçlara yol açabilir!
Uzmanlar reçetesiz satılsa bile vitamin takviyelerinin doktor tavsiyesi olmadan kullanılmamasını öneriyor.
Zira; bilinçsiz kullanılan vitamin takviyeleri böbrek ve karaciğer rahatsızlığına kadar uzanabilecek ciddi sorunlara sebebiye verebilir.
Vatandaşların bu dönemlerde çok fazla besin ve gıda takviyelerini kulladığını ifade eden Uzman hekimler, "Bunların bir kısmının faydası var fakat çoğu ya gereksiz ya da bazen bizim vücudumuza zararı olabiliyor" görüşünde.
Ayrıca, bir doktora başvurup tahlil yaptırdıktan sonra hangi eksiklerimiz olduğunu tespit etmemiz gerektiğine dikkat çekerken şöyle ifade ediyorlar, "Belki de bir demir eksikliğiniz var, belki sadece D vitamini eksikliğiniz var ona yönelik gıda takviyeleri kullanmanız sizin faydanıza olacaktır."

Henüz yorum yok. İlk yorumu siz yazın!
Yorum Yazın